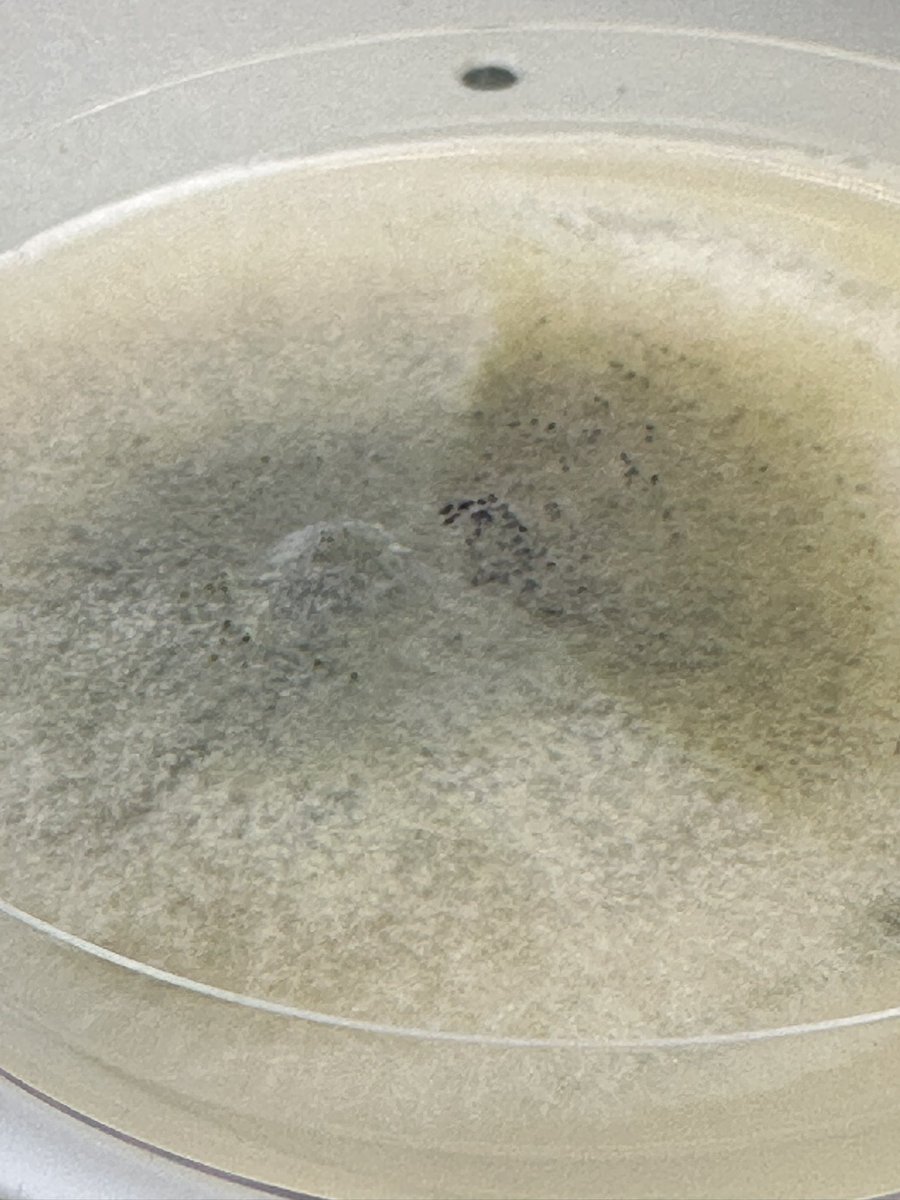
Next up-blackleg! <a href="/canolacouncil/">Canola Council of Canada</a> <a href="/BASFAgSolutions/">BASF Agricultural Solutions Canada</a> #CanoLab

Leighton Blashko
@leightonblashko
Technical Lead -cereal and pulse herbicides for Syngenta. Also involved in family farm in Alberta - canola, wheat, peas, barley
ID: 467072826
18-01-2012 02:56:02
1,1K Tweet
1,1K Takipçi
1,1K Takip Edilen

New pest in #canola at #canolaweek2023 presented by @BoydMori Know the symptoms, scout your fields. BASF Agricultural Solutions Canada CW Jay Whetter



🎅🎄Ryan keeps the the sleigh rolling with Day #11 of the 12 Days of Christmas. For today we have a 20 piece metric combination wrench set from John Deere USA & the What the Futures. 💚 this to get entered to win repost for a second entry. Draw 8pm mtn tonight. Watch the video here










Only a few days left!! March 18 deadline for submissions #BASFGrowingHome $25,000 for a rural community project. BASF Agricultural Solutions Canada Submit your application at agsolutions.ca/growinghome

🌾Mark your calendars and help spread the word🌾 University of Alberta Annual Field Day - July 18, 2024 Our Crop Unit of UAlberta Faculty of ALES will showcase wheat variety development, agronomy & soil science research at South Campus (Edmonton Research Station) + St. Albert Research Farms.


Ready for a day of canola diseases! Great learning opportunity at #CanoLab Canola Council of Canada BASF Agricultural Solutions Canada UAlberta Faculty of ALES



Sclerotinia Stem Rot is the next of the Big 4 #canola diseases. Canola Council of Canada #CanoLab #golfteeapothecia





66 lb Red Spring Wheat off the 3 mile long yard field. 👍 Syngenta Canada there is a Miravis commercial in here somewhere.